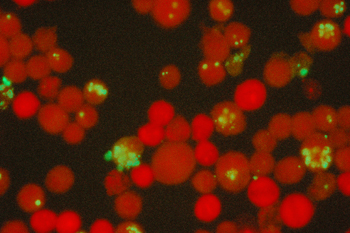

|

|
GENTAUR
 +32 1658 9045 +32 1658 9045
or
0032 (0)16 41 44 07
 +32 1650 9045 +32 1650 9045
[email protected]
Av. de l' Armée 68
B-1040 Brussels
BELGIUM

France
tel 01 43 25 01 50
fax01 43 25 01 60
9, rue Lagrange
75005 Paris

Italia
tel 02 36 00 65 93
fax 02 36 00 65 94
20135 Milano

Deutschland
tel +32 1658 9045
fax +32 1650 9045

Polska
Tel 058 710 33 44
Fax 00 32 16 50 90 45
ul. Grunwaldzka 88A/2
81-771 Sopot

日本
tel +81 78 386 0860
fax +81 78 306 0296
Minaatojimaminami-manchi
Chuo-ku, Kobe
065-0047


Österreich
+43720880899
Canada Montreal
+15149077481
Česká republika Praha
+420246019719
Danmark
+4569918806
Finland Helsset
+358942419041
Ελλάς Αθήνα
+302111768494
Magyarország Budapest
+3619980547
Ireland Dublin
+35316526556
Luxembourg
+35220880274
Nederland
+31208080893
Norge Oslo
+4721031366
Polska Warszawa
+48223988221
Sverige Stockholm
+46852503438
Schweiz Züri
+41435006251
US New York
+17185132983
Other Countries
0032 (0)16 41 44 07
|
|
| |
Ehrlichia / Anaplasma / Neorickettsia

|
| |
|
E.
canis + A. phagocytophilum MIF Antibody Test Kits |
|
Each slide well contains
2 separate antigen spots, with elementary bodies of
each antigen within an contrasting background
matrix. Kits are formatted for 120 x 2 tests and
contain titered Controls, working FITC Conjugate,
Mounting Medium, Wash Buffer and Instructions for
use. |
 |
|
Anaplasma phagocytophilum IFA Antibody Test Kits |
|
Kits are formatted for
120 tests and contain titered Controls, working FITC
Conjugate, Mounting Medium, Wash Buffer and
Instructions for use. |
|
Ehrlichia canis IFA Antibody Test Kits |
|
Kits are formatted for
120 tests and contain titered Controls, working FITC
Conjugate, Mounting Medium, Wash Buffer and
Instructions for use. |
|
SUBSTRATE SLIDES: |
|
Ehrlichia canis,
Neorickettsia risticii and Anaplasma phagocytophilum
are seen as morulae in the cytoplasm of
cultured human monocytes. |
|
Anaplasma phagocytophilum IFA Control Set |
|
Controls are in dropper bottles
containing 0.5 mL each. The Positive Control gives
strong fluorescence as bottled and should titer
8-fold further. Negative Control is considered
non-reactive as bottled. |
|
Ehrlichia canis IFA Control Set |
|
Controls are in dropper bottles
containing 0.5 mL each. The Positive Control gives
strong fluorescence as bottled and should titer
8-fold further. Negative Control is considered
non-reactive as bottled. |

|
Product |
Unit Size |
Description |
|
Ehrlichia canis + Anaplasma phagocytophilum MIF |
|
E2D-120 |
120 x 2 tests |
E. canis + A. phagocytophilum MIF IgG Antibody
Test Kit |
|
E2-12 |
each |
E.
canis + A. phagocytophilum MIF 12-well Substrate
Slides |
|
Ehrlichia canis |
|
ECG-120 |
120 tests |
Ehrlichia canis IFA IgG Antibody Test Kit |
|
ECM-120 |
120 tests |
Ehrlichia canis IFA IgM Antibody Test Kit |
|
EC-12 |
each |
Ehrlichia canis IFA Substrate Slides (12-well) |
|
CG-25 |
each |
Working anti-canine IgG (H) IFA Conjugate, 2.5 mL |
|
EC-GC |
1 each |
Ehrlichia canis IFA IgG Canine Controls, 0.5 mL
each |
|
Ehrlichia equi (Anaplasma phagocytophilum) |
|
EED-120 |
120 tests |
Anaplasma phagocytophilum IFA Antibody Test Kit
|
|
EE-12 |
each |
Anaplasma phagocytophilum IFA Substrate Slides
(12-well) |
|
Ehrlichia (Neorickettsia) risticii |
|
ER-12 |
each |
Neorickettsia risticii substrate slides (12-well) |
|
|